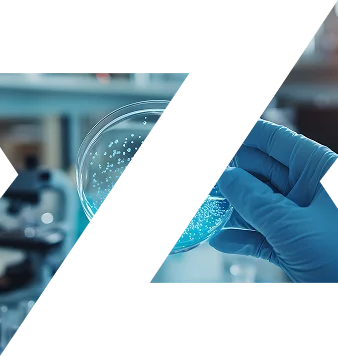

מערכת האוויר הנשימתי של Parker מספקת אוויר דחוס באיכות נשימה, לפי התקנים המחמירים בעולם.
היא מיועדת להבטיח סביבת עבודה בטוחה במצבים שבהם איכות האוויר היא תנאי בסיסי לתפקוד, ממפעלים תעשייתיים ועד חדרים נקיים ומוסדות רפואיים.
המערכת מטהרת את האוויר ב-7 שלבים, מסירה 15 מזהמים מזיקים, שומרת על לחות נמוכה, ומספקת זרימה רציפה של אוויר נקי, יבש ובטוח בכל רגע.